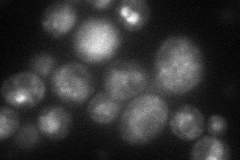
YKL034W
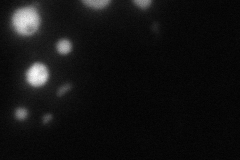
YKL034W
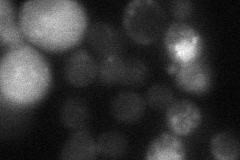
YKL034W

View description
Golgi-localized RING-finger ubiquitin ligase (E3), involved in ubiquitinating and sorting membrane proteins that contain polar transmembrane domains to multivesicular bodies for delivery to the vacuole for quality control purposes
Localization:
Intensity:
Fold change:
Significance:
-
C’ GFP library in SD

below threshold16.96 -
N' NOP1pr-GFP in SD
punctate,vacuole49.634 -
N' TEF2pr-mCherry in SD
vacuole27.9007 -
N' NATIVEpr-GFP in SD
ER,punctate,vacuole63.0506 -
N' TEF2pr-VC and Cyto-VN in SD

#N/A0 -
C’ GFP library in SD+DTT

cytosol16.280.96No -
C’ GFP library in SD+H2O2

cytosol16.350.96No -
C’ GFP library in Starvation Media

cytosol15.480.91No -
C’ GFP library on the background of Pup2-DaMP

below threshold -
C’ GFP library on the background of CCT mutant

below threshold17.86371.05298No
